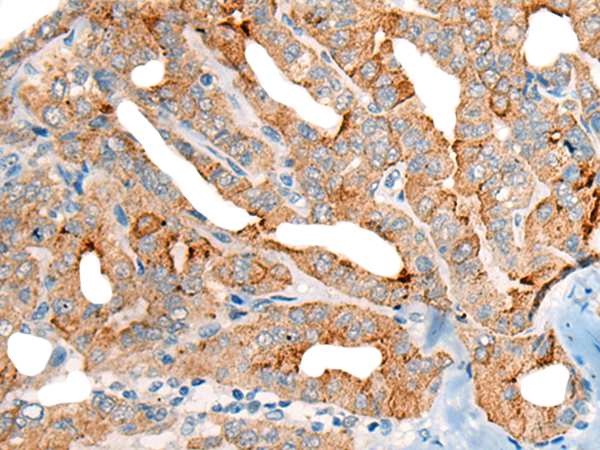

-
分类: 科研抗体货号: P02456别名: SHK; CARKL应用: WB,IHC反应种属: Human, Mouse
-
分类: 科研抗体货号: P02504别名: FHR2; HFL3; CFHL2应用: WB,IHC反应种属: Human
-
分类: 科研抗体货号: P02498别名: CEN3; CDC31应用: WB,IHC反应种属: Human, Mouse
-
分类: 科研抗体货号: P02487别名: HEPP; SEI-3/HEPP应用: WB,IHC反应种属: Human
-
分类: 科研抗体货号: P02561别名: ER1; MI-ER1应用: WB,IHC反应种属: Human, Mouse
-
分类: 科研抗体货号: P02481别名: 4F2; CD98; MDU1; 4F2HC; 4T2HC; NACAE; CD98HC应用: WB,IHC反应种属: Human
-
分类: 科研抗体货号: P02557别名: CRN7; POD1; 0610011B16Rik应用: WB,IHC反应种属: Human, Mouse, Rat
-
分类: 科研抗体货号: P02476别名: T3G; IMD17; CD3-GAMMA应用: WB反应种属: Human, Mouse
-
分类: 科研抗体货号: P02555别名: IR10; WDR2; CLIPINB应用: WB反应种属: Human
-
分类: 科研抗体货号: P02473别名: CPR4应用: WB,IHC反应种属: Human

鄂公网安备42018502007531号
鄂公网安备42018502007531号

